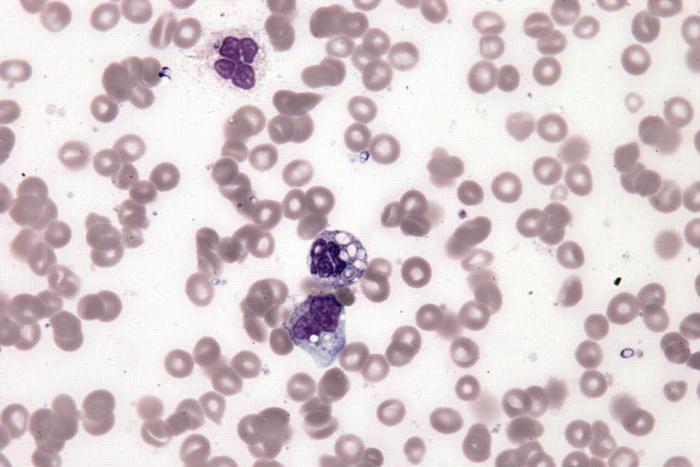

Лейкемоїдні реакції – зміни гемопоезу, подібні з картиною крові при лейкозах та інших пухлинах кровотворної системи. Слід зауважити, що специфічністю даних впливів вважається їх активна спрямованість і відсутність переходу в онкологічну патологію. Ці реакції можуть бути спровоковані різного виду інтоксикаціями, пухлинами, інфекціями, метастазами раку головного мозку.
Механізм розвитку неоднаковий при різних типах реакцій: в одних випадках це вихід в кров незрілих клітинних елементів, в інших — підвищена продукція клітин крові або обмеження виходу клітин в тканини, або наявність декількох механізмів одночасно.

Що може бути джерелом захворювання?
Є чимало факторів, внаслідок яких можуть з’явитися лейкемоїдні реакції. Причини їх розвитку такі:
- вплив іонізуючої радіації;
- туберкульоз;
- сепсис;
- гнійні процеси;
- дизентерія;
- лімфогранулематоз;
- травми черепа;
- шоковий стан;
- крупозна пневмонія;
- рожа;
- дифтерія;
- скарлатина;
- гостра дистрофія печінки;
- терапія кортикоїдними гормонами;
- отруєння чадним газом.
Різновиди хвороби
Розрізняють наступні види лейкемоидных реакцій:
- Мієлоїдний реакції.
- Лімфоцитарні.
- Псевдобластные.
Розглянемо кожен з них детальніше.

Мієлоїдний
До даного типу відносяться такі реакції, як нейтрофільні, промиелоцитарные та еозинофільні. Лейкемоїдні впливу, схожі з хронічним мієлолейкозом, супроводжуються інтоксикаціями і важкими інфекціями. Активний лейкоцитоз у своїй основі завжди має складний процес, що супроводжується наявністю сепсису, запальних вогнищ та збільшенням температури тіла.
Дії з перевищенням еозинофілів у крові, як правило, виникають при сенсибилизациях до паразитів і ліків, алергічних діатезах, рідко – при онкозахворюваннях (лімфогранулематоз і лимфосаркомах). Дані лейкемоїдні реакції потребують всебічного обстеження для усунення хвороб кровоносної системи і гельмінтів.
Реактивні клітини подібні еритремії. Фактори еритроцитоз – це найчастіше нездужання легень із зменшенням оксигенації (кислородонасыщения) крові, пухлини нирок, а також вроджені вади серця. В даній ситуації потрібно комп’ютерне та ультразвукове дослідження.
Міелемія схожа з гострим эритромиелозом, яка відрізняється лише недоліком бластних еритроцитів в кістковому мозку і крові. Нерідко її можна виявити при метастазах хвороби кістки.
Лімфоцитарні
Такі реакції характеризуються суттєвим зростанням усієї кількості лімфоцитів в периферійній крові, що досить часто відповідає за збільшення печінки, лімфатичних вузлів та селезінки.
До даного типу відносяться мононуклеоз, інфекційний лімфоцитоз, моноцитарно-макрофагальные лейкемоїдні реакції у дітей при бактеріальних, вірусних інфекціях, а також паразитних заражених і великі еозинофілії крові (наприклад, при гельмінтозах).
Лімфоцитарні реакції з’являються:
- при вірусних інфекціях (вітряної віспи, краснухи, епідемічному паротиті, аденовірусної інфекції, кору, інфекційному мононуклеозі);
- паразитарних інфекціях (риккетсиозах, токсоплазмозі, хламідіоз);
- бактеріальних інфекціях (сифілісі, коклюші, туберкульозі);
- різних мікозах;
- аутоімунних хворобах (сироватковому захворюванні, системному червоному вовчаку).
Лімфоцитарний тип ще зустрічається при макроглобулінемія Вальденстрема, запальних процесах, саркоїдозі. Всі перераховані вище нездужання лікуються дуже важко і можуть турбувати пацієнта не один рік.
Псевдобластные
Такі лейкемоїдні реакції зустрічаються, якщо хворий тільки починає виходити з імунного агранулоцитозу, причина якої може бути викликана прийомом сульфаніламідів, «Амідопірину», «Бутадіону» та інших препаратів.
Для такої групи впливів характерно присутність у периферичній крові і кістковому мозку чималого числа клітинних складових з гомогенним ядром, одиничними нуклеоламі і блакитний, тонкої, не має зернистості цитоплазмою.
На відміну від характерних бластних еритроцитів у цих немає специфічної м’якою мережі і розміреності хроматиновых волокон. Непостійні бластозы, зникаючі без хіміотерапії і відносяться до лейкемоідной впливів, виявляються у новонароджених малюків з генетичними порушеннями хромосом (наприклад, синдром Дауна).

Лейкемоїдні реакції, типи яких представлені вище, що формуються на тлі будь-якої патології, зазвичай небезпечних ускладнень не провокують. Іноді різко з’явилася тромбоцитопенія може помилково розцінюватися як один з ознак гострого лейкозу. У виявленні иммунобластных лімфаденітів чималу значимість має безпеку природного будови лімфатичного вузла, а також точно визначаються лінії фолікулів.
Лейкемоїдні реакції і лейкоз: відмінності
Існують деякі відмінності між такими діями і лейкоз, а саме:
- При лейкемоидных реакціях відсутня швидке омолодження кісткового мозку, він є метамиелоцитарным, а при лейкозі виявляється збільшення бластних форм. При лейкемоидных впливах збережений эритроидный росток, існує нормальне лейкоэритробластическое співвідношення – 3:1 і 4:1.
- Не спостерігається проявлена анаплазія при лейкемоидных явищах, як це буває при лейкозі, коли відбувається випинання протоплазми і аномалія ядра.
- У першому варіанті в периферичній крові спостерігається зростання абсолютного числа і збільшення процентного вмісту зрілих нейтрофілів, при лейкозах зменшується вміст зрілих нейтрофілів, відбувається надмірна проліферація молодих, незрілих форм.
- При лейкемоидных реакціях часто відзначається токсична зернистість нейтрофілів.
- При цитохимическом дослідженні лейкоцитів при лейкозах спостерігається зниження або відсутність лужної фосфатази, при лейкемоидных реакціях – підвищена активність.
- При загостренні хронічного мієлолейкозу передвісником бластного кризу є еозинофільно-вазофільна асоціація, при лейкемоидных реакціях вона відсутня.
- При миелолейкозах часто спостерігається високий тромбоцитоз, при лейкемоидных реакціях кількість тромбоцитів в межах норми.
- На початкових стадіях хронічного мієлолейкозу виявляють велику щільну селезінку, при лейкемоидных реакціях іноді також буває спленомегалія, але даний орган м’який і ніколи не досягає дуже великих розмірів.
- При лейкемоидных реакціях на неопластический процес у кістковому мозку виявляються ракові клітки.

Лейкемоїдні реакції у дітей: алгоритм діагностики
Важлива роль у діагностиці даного захворювання відводиться патогістології, який досліджує матеріал біопсії. Але щоб не припуститися непоправної помилки, патологоанатом повинен зібрати достовірну інформацію про пацієнта, дати йому направлення на різні аналізи і призначити цитостатичне лікування, яке прибере всі наслідки лімфаденіту. Якщо всього цього не зробити, то діагноз буде поставлений неправильно, а тому впоратися з недугою буде дуже складно. Адже таке захворювання дуже небезпечно. Іноді для деталей висновку необхідно проводити повторну біопсію.
Чимале значення в діагностиці має мазок з зовнішності біопсірованной лімфатичного вузла і відбиток. При лімфосаркомі більшу частину еритроцитів (мінімально 30 відсотків) складають постійні бластні клітини. При імунобластні лімфаденіті такі еритроцити, як правило, менше 10 відсотків, вони різні за показниками базофілія цитоплазми і зрілості ядра.
Патогістологічний діагноз з аналізу лімфатичного вузла повинен бути дуже детальним і виключає неточне висновок. Тому що патогістолог за різними дослідженнями крові повинен чітко визначити діагноз, і це відбивається в ув’язненні. Наприклад, для встановлення первинного діагнозу доброякісних лімфом у деяких випадках потрібно довго спостерігати за хворим і обстежити лімфатичні вузли вдруге.

Діагностика лейкемоидных реакцій, підозрюваних при виявленні моноклонального імуноглобуліну, іноді вимагає багаторічних спостережень і повторних пункцій кісткового мозку. До затвердження діагнозу протипухлинне лікування протипоказано.
Інфекційний мононуклеоз
Ще називається захворюванням Філатова – Пфейферра, залозистої гарячки та моноцитарній ангіною. Є вірусною хворобою, яка характеризується бласттрансформації лімфоцитів, збільшенням лімфатичних вузлів і селезінки, реактивним лімфаденітом, виникненням специфічних еритроцитів у периферичній крові. Збудником вважається вірус Епштейна-Барра. На підставі недуги – бласттрансформації лімфоцитів, викликана особливою вірусною інфекцією.
Клінічна ситуація різна. В легких формах порушується самопочуття внаслідок риніту. Показові ознаки:
- ангіна («палаючий зів»);
- збільшення селезінки і шийних лімфатичних вузлів, а також їх болючість;
- важкий носове дихання в перші дні захворювання за рахунок припухлості слизової оболонки.
Стан крові: підвищення відсотка еозинофілів, лімфоцитів і моноцитів.
Ускладнення
Необхідним і достатнім для укладання показником хвороби вважається наявність в крові своєрідних мононуклеарів (понад 10-20 %) – клітин, що відрізняються ядром великого лімфоцита і широкої базофильной з бузковим кольором цитоплазмою з вираженим перінуклеарним проясненням. Тривають лейкемоїдні реакції у дітей і дорослих кілька тижнів, однак у певних ситуаціях нормалізація стану крові триває місяці.
Спостерігаються і рецидиви з більш легким перебігом, іноді з інтервалами в кілька років після першого гострого періоду. Ускладненнями можуть бути:
- гострий гепатит;
- енцефаліт;
- агранулоцитоз;
- розрив селезінки, викликаний її швидким збільшенням;
- аутоімунний гемоліз.
Терапія лейкемоидных реакцій
Як правило, пацієнтам не потрібно спеціальне медикаментозне лікування, тому що протягом декількох днів головні ознаки захворювання зникають і стан крові нормалізується. При тривалої хвороби і поганому самопочутті хворого використовують патогенетичну терапію – призначають «Преднізолон» в дозуванні по 20-30 міліграмів на добу або інші глюкокортикоїдні препарати, щоб усунути лейкемоїдні реакції. Лікування у кожному випадку призначає тільки фахівець.
Прогноз
Зазвичай позитивний: контагіозність невелика, і тому карантин пацієнта необов’язковий. Проте дуже небезпечні розриви селезінки. Відновлення працездатності визначається появою ознак скорочення обсягів органу, а також зникненням ангіни і нормалізацією температури тіла. Якщо інфекційний мононуклеоз проявляється у вигляді гепатиту, потрібна госпіталізація хворого.





